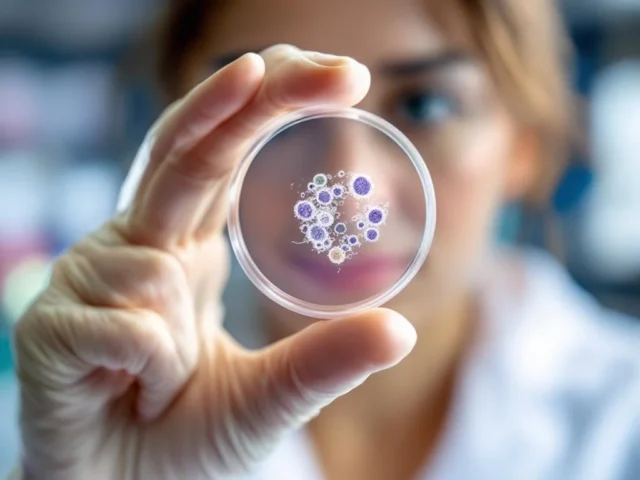

Un lymphome est un type de cancer qui affecte le sang et le système lymphatique, celui-ci jouant un rôle clé dans le système immunitaire.
Qu’est-ce qu’un lymphome ?
Le lymphome est une tumeur maligne qui touche le système lymphatique, composé notamment de lymphocytes, des globules blancs responsables de la défense de l’organisme. Ce cancer résulte d’une multiplication anormale de cellules lymphoïdes, qui peut survenir dans les ganglions lymphatiques ou dans d’autres organes lymphoïdes comme la rate, le foie, ou la moelle osseuse. Il existe deux grands types : le lymphome hodgkinien, aussi appelé maladie de Hodgkin, représentant 20% des cas, et le lymphome non hodgkinien, qui en représente 80%.
Le lymphome hodgkinien : 20% des cas
Ce type de lymphome se caractérise par la présence d’une cellule particulière, la cellule de Sternberg, dans l’organe atteint. Il touche principalement les adolescents et les jeunes adultes, notamment entre 20 et 40 ans. Le cancer se déroule en quatre stades, allant d’une atteinte limitée à un seul groupe ganglionnaire à une atteinte plus étendue touchant plusieurs organes. Bien qu’agressif, il bénéficie d’un taux de guérison supérieur à 80%.
Le lymphome non hodgkinien : 80% des cas
Ce lymphome, beaucoup plus fréquent, se développe à partir de lymphocytes B ou T. La majorité des cas concerne des adultes de plus de 50 ans. La plupart du temps, il se manifeste par des gonflements de ganglions, une augmentation de la taille de la rate ou du foie. Le diagnostic repose sur une biopsie de ganglion, qui permet d’identifier le type précis de lymphome.
Les sous-types de lymphomes non hodgkiniens
Le lymphome B à grandes cellules
Ce groupe comprend des lymphomes qui se développent à partir des lymphocytes B, avec une classification selon leur agressivité : lymphomes indolents ou agressifs.
Le lymphome du manteau
Ce lymphome concerne principalement les hommes de plus de 50 ans. Il se présente souvent sous une forme indolente mais peut être plus grave. Il nécessite une chimiothérapie, parfois suivie d’une greffe de moelle. En cas de rechute, une thérapie ciblée peut être efficace.
Le lymphome folliculaire
Souvent localisé dans les ganglions périphériques, il apparaît généralement vers 55 ans. Ce lymphome évolue lentement et peut rester asymptomatique pendant des années. Le traitement peut inclure l’immunothérapie ou la chimiothérapie, surtout si des symptômes apparaissent ou si un organe vital est menacé.
Le lymphome de Burkitt
Il existe en deux formes : endémique, fréquente en Afrique, souvent liée au virus Epstein-Barr, et sporadique, plus rare, touchant principalement les enfants. Ce lymphome est généralement très sensible à la chimiothérapie, avec un bon pronostic.
Le lymphome cutané
Ce type rare se manifeste par des tumeurs sur la peau, principalement chez des personnes de plus de 60 ans. Il peut apparaître sous forme de plaques rouges, nodules ou rougeurs diffuses. La biopsie permet de confirmer le diagnostic, et le traitement dépend du type précis de lymphome cutané.
Quels sont les symptômes ?
Les principaux signes sont un gonflement indolore des ganglions, notamment au cou, aux aisselles ou à l’aine. Des symptômes plus graves incluent des troubles respiratoires ou digestifs liés à la compression, de la fièvre, des sueurs nocturnes et une perte de poids. La survenue de ces symptômes doit conduire à consulter un spécialiste, surtout si un ou plusieurs ganglions augmentent de volume.
Quelles en sont les causes ?
Les lymphomes apparaissent suite à une multiplication incontrôlée de lymphocytes B. Les facteurs de risque incluent le vieillissement, un système immunitaire affaibli (notamment chez les porteurs du VIH ou sous traitement immunosuppresseur), ou encore certaines infections comme l’hépatite C ou Helicobacter pylori, associées à certains types de lymphomes.
Comment diagnostique-t-on un lymphome ?
Le diagnostic peut être difficile. La présence d’une grosseur au niveau d’un ganglion ou d’un organe, accompagnée de symptômes comme la perte de poids ou la fièvre, peut évoquer un lymphome. Un scanner permet d’identifier des adénopathies, et une biopsie de ganglion, analysée en laboratoire, confirme la nature de la tumeur et détermine le type précis. La biopsie permet également de conserver un échantillon pour des analyses futures.
Quels sont les traitements ?
Le traitement est décidé par une équipe de spécialistes lors d’une réunion de concertation. Il repose principalement sur la chimiothérapie, associée parfois à une immunothérapie. Selon le cas, une radiothérapie ou une greffe de moelle peut être proposée. Le suivi médical est régulier, avec des examens pour vérifier l’efficacité du traitement. L’objectif est d’atteindre une rémission totale, avec la possibilité de guérison après plusieurs années.